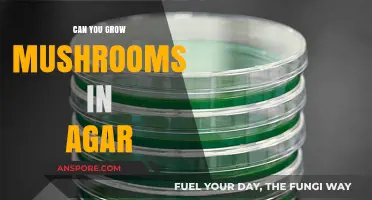
Growing Mushrooms in Agar: A Beginner's Guide to Mycelium Cultivation

Growing mushrooms in a shipping container has become an increasingly popular and innovative method for cultivating fungi in controlled environments. Shipping containers offer a unique solution for urban and small-scale farmers due to their portability, durability, and ability to be modified into fully functional growing spaces. By equipping these containers with proper insulation, ventilation, humidity control, and lighting systems, cultivators can create optimal conditions for mushroom growth year-round, regardless of external weather conditions. This approach not only maximizes space efficiency but also allows for precise monitoring and adjustment of environmental factors, leading to higher yields and consistent quality. Whether for commercial production or personal use, repurposing shipping containers for mushroom cultivation represents a sustainable and scalable way to meet the growing demand for fresh, locally grown mushrooms.
| Characteristics | Values |
|---|---|
| Feasibility | Yes, mushrooms can be grown in shipping containers. |
| Space Utilization | Efficient use of vertical space with stacked growing shelves. |
| Climate Control | Requires HVAC systems for temperature (55-75°F / 13-24°C) and humidity (50-90%) control. |
| Lighting | Low-energy LED lights sufficient; natural light not necessary. |
| Ventilation | Essential for air exchange and CO2 management; exhaust fans and filters needed. |
| Substrate Preparation | Sterile environment required for substrate (e.g., straw, sawdust) preparation. |
| Mushroom Varieties | Suitable for oyster, shiitake, lion's mane, and other varieties. |
| Yield Potential | Up to 2-3 lbs (0.9-1.4 kg) per square foot per harvest cycle. |
| Harvest Cycles | 4-8 weeks depending on mushroom type. |
| Initial Investment | $10,000-$50,000 for setup (container, equipment, substrate). |
| Operational Costs | $1,000-$3,000/month (electricity, substrate, labor). |
| Sustainability | Eco-friendly with potential for waste-to-substrate conversion. |
| Scalability | Easily scalable by adding more containers. |
| Regulations | Subject to local zoning, food safety, and agricultural regulations. |
| Market Demand | High demand for specialty and organic mushrooms. |
| Challenges | Maintaining sterile conditions, pest control, and consistent climate. |
Explore related products
$37.99
What You'll Learn
- Optimal Container Conditions: Temperature, humidity, light, and ventilation requirements for mushroom cultivation in containers
- Substrate Preparation: Choosing and preparing growing mediums like straw, sawdust, or compost for mushrooms
- Mushroom Species Suitability: Best mushroom varieties (e.g., oyster, shiitake) for container farming
- Pest and Disease Control: Managing contaminants and pests in a confined container environment
- Harvesting and Yield: Techniques for maximizing mushroom yield and proper harvesting methods in containers

Optimal Container Conditions: Temperature, humidity, light, and ventilation requirements for mushroom cultivation in containers
Mushroom cultivation in shipping containers demands precise environmental control to mimic the fungi's natural habitat. Temperature is critical: most mushroom species thrive between 55°F and 65°F (13°C–18°C) during the fruiting stage, though spawn colonization often requires slightly warmer conditions, around 70°F–75°F (21°C–24°C). Deviations outside these ranges can stall growth or encourage contaminants. For instance, oyster mushrooms (Pleurotus ostreatus) are forgiving, tolerating a broader range, while shiitake (Lentinula edodes) require stricter adherence to cooler temperatures. Automated thermostats or insulated containers with heating/cooling systems are essential for maintaining consistency, especially in regions with extreme climates.
Humidity levels are equally vital, as mushrooms are 90% water and require a moist environment to develop. Relative humidity should hover between 85% and 95% during fruiting, with misting systems or humidifiers often employed to prevent drying. However, excessive moisture invites mold and bacteria, necessitating a delicate balance. Substrate moisture content is equally important; it should be around 60–70% to support mycelial growth without waterlogging. Hygrometers and automated misting schedules can help, but manual monitoring remains crucial, particularly during pinning and fruiting stages when mushrooms are most sensitive.
Light requirements for mushrooms are minimal but purposeful. Indirect, diffused light—mimicking a forest floor—triggers fruiting bodies to form. Six to eight hours of low-intensity LED or natural light through translucent container panels suffices. Direct sunlight is detrimental, as it raises temperatures and dries substrates. Light cycles can be manipulated to encourage synchronized fruiting, a technique often used in commercial setups. For example, button mushrooms (Agaricus bisporus) respond well to consistent light exposure, while some exotic species may require specific photoperiods to initiate fruiting.
Ventilation is the unsung hero of container-based mushroom cultivation, preventing carbon dioxide buildup and ensuring fresh air exchange. Mushrooms respire, consuming oxygen and releasing CO2, which can inhibit growth if concentrations exceed 1,000 ppm. Passive vents or active exhaust fans should be installed to create a slight negative pressure, drawing in fresh air while expelling stale gases. Airflow must be balanced to avoid drying substrates; a rule of thumb is 1–2 air changes per hour. Filtration systems are also critical to prevent airborne contaminants from entering the container, with HEPA filters being a gold standard for sterile environments.
In practice, integrating these conditions into a shipping container requires careful planning and technology. Insulation, climate control systems, and monitoring sensors are non-negotiable investments. For instance, a 20-foot container can support up to 1,000 pounds of substrate, yielding 200–400 pounds of mushrooms per flush, but only if conditions are meticulously managed. Case studies from urban farms in Brooklyn and Amsterdam demonstrate that with proper setup, containers can outpace traditional growing methods in efficiency and yield. However, the learning curve is steep, and beginners should start with resilient species like lion's mane or oyster mushrooms before scaling up.
Creamy Mushroom Sauce: Sour Cream's Role in Elevating Your Dish
You may want to see also

Substrate Preparation: Choosing and preparing growing mediums like straw, sawdust, or compost for mushrooms
Straw, sawdust, and compost are the unsung heroes of mushroom cultivation, each offering unique advantages for the discerning grower. Straw, particularly wheat or rye, is a favorite for oyster mushrooms due to its high cellulose content and ease of pasteurization. Simply soak the straw in hot water (60-70°C) for an hour to eliminate competitors, drain, and cool before inoculation. Sawdust, often paired with supplements like bran or gypsum, is ideal for shiitake and other wood-loving species. Sterilization in an autoclave at 121°C for 90 minutes ensures a clean substrate, though this method requires more equipment. Compost, rich in nutrients, suits button and cremini mushrooms but demands precise preparation. Mix horse manure, straw, and water in a 10:3:1 ratio, then compost for 3-4 weeks, turning regularly to achieve a temperature of 60-70°C, killing pathogens while retaining fertility.
The choice of substrate hinges on the mushroom species and your resources. For instance, oyster mushrooms thrive on straw, which is affordable and widely available, making it a go-to for beginners. Sawdust, while more labor-intensive, offers versatility and is perfect for long-term, log-based cultivation. Compost, though nutrient-dense, requires meticulous management to avoid contamination. Consider your container’s climate control capabilities: straw and sawdust retain moisture well in dry environments, while compost’s high water content may necessitate additional drainage in humid settings.
Preparation is as critical as selection. Pasteurization and sterilization are not interchangeable. Pasteurization, suitable for straw, reduces microbial competitors without killing all life, preserving beneficial microorganisms. Sterilization, essential for sawdust, creates a completely sterile environment, crucial for species sensitive to contamination. For compost, the composting process itself acts as a natural pasteurization method, breaking down organic matter and eliminating pathogens. Always test your substrate’s pH (optimal range: 5.5-6.5) and moisture content (60-70%) before inoculation to ensure mushroom mycelium can colonize effectively.
In a shipping container, space and efficiency matter. Straw bales can be stacked vertically, maximizing floor space, while sawdust-based substrates often come in bags, allowing for modular arrangement. Compost, being heavier, benefits from raised beds or trays with drainage. Incorporate a layer of vermiculite or perlite to regulate moisture, especially in closed environments where humidity can spike. Regular monitoring with a hygrometer and thermometer ensures the substrate remains within optimal conditions, fostering healthy mycelium growth and bountiful harvests.
Ultimately, substrate preparation is both art and science, demanding attention to detail and adaptability. Whether you’re pasteurizing straw in a bathtub or sterilizing sawdust in an autoclave, the goal is to create a nurturing environment for mushrooms to flourish. In the confined yet controlled space of a shipping container, the right substrate choice and preparation can turn a metal box into a thriving fungal farm. Experiment with small batches, document your process, and refine your techniques—success lies in understanding the unique needs of your chosen substrate and mushroom species.
Baking Lion's Mane Mushrooms: Tips, Recipes, and Delicious Results
You may want to see also

Mushroom Species Suitability: Best mushroom varieties (e.g., oyster, shiitake) for container farming
Growing mushrooms in a shipping container is not only feasible but also highly efficient, provided you choose the right species. The controlled environment of a container allows for precise regulation of temperature, humidity, and light, which are critical for mushroom cultivation. However, not all mushroom varieties thrive under these conditions. Species like oyster and shiitake are particularly well-suited due to their adaptability and rapid growth cycles. Oyster mushrooms, for instance, can colonize substrate in as little as 14 days and fruit within 7–10 days, making them ideal for container farming where space and time are optimized.
When selecting mushroom species for container farming, consider their environmental requirements and growth habits. Shiitake mushrooms, while slightly more demanding, are highly profitable and can be grown on hardwood sawdust or logs. They require a lower temperature range (55–65°F) during colonization and higher humidity (85–95%) during fruiting. In contrast, lion’s mane mushrooms prefer cooler temperatures (50–60°F) and are known for their unique appearance and medicinal properties. Each species has specific needs, so matching them to your container’s capabilities is essential for success.
For beginners, oyster mushrooms are the most forgiving and versatile choice. They tolerate a wider range of conditions, including temperatures between 60–75°F and humidity levels above 80%. Their ability to grow on a variety of substrates, such as straw, coffee grounds, or sawdust, makes them accessible for small-scale operations. Additionally, oyster mushrooms are highly productive, yielding up to 2–3 pounds of mushrooms per square foot of growing space in a single flush. This makes them a cost-effective option for maximizing container space.
While oyster and shiitake mushrooms are popular choices, other varieties like button mushrooms and enoki can also be grown in containers, though they require more precise conditions. Button mushrooms, for example, need a cooler environment (55–60°F) and a casing layer of peat moss or compost to fruit successfully. Enoki mushrooms thrive in colder temperatures (45–55°F) and low light, making them more challenging but rewarding for experienced growers. Each species offers unique advantages, so diversifying your container farm with multiple varieties can increase profitability and appeal to a broader market.
In conclusion, the key to successful container mushroom farming lies in selecting species that align with your container’s environmental controls and your market demand. Oyster mushrooms are an excellent starting point for their ease and productivity, while shiitake and lion’s mane offer higher profit margins with slightly more effort. By understanding the specific needs of each variety and tailoring your setup accordingly, you can create a thriving, sustainable mushroom farm within the confines of a shipping container.
Daily Mushroom Coffee: Safe, Beneficial, or Overhyped? Let's Explore
You may want to see also
Explore related products
$43.76

Pest and Disease Control: Managing contaminants and pests in a confined container environment
Growing mushrooms in a shipping container offers a controlled environment ideal for maximizing yield, but this confined space also amplifies the risk of pests and diseases. Unlike open-air cultivation, containers create a microclimate where contaminants can spread rapidly, threatening entire crops. Effective pest and disease management is therefore critical to success.
One key strategy involves maintaining strict hygiene protocols. Before introducing mushroom substrate, thoroughly clean and disinfect the container using a 10% bleach solution or a commercial disinfectant. All tools, surfaces, and even clothing should be sanitized regularly to prevent the introduction of spores or pests. Implementing a "clean room" protocol, where workers wear sterile suits and footwear, can further minimize contamination risks.
Airflow management is another crucial aspect. While mushrooms thrive in humid conditions, stagnant air fosters mold and mildew growth. Install a ventilation system with HEPA filters to circulate fresh air while trapping airborne spores and pests. Aim for a minimum of six air exchanges per hour, ensuring a constant flow without creating drafts that could stress the mushrooms. Additionally, consider using UV-C light sterilization within the ventilation system to neutralize pathogens.
For biological pest control, introduce beneficial organisms like predatory mites or nematodes that target common mushroom pests such as fungus gnats or sciarid flies. These natural predators can be applied at a rate of 1,000 mites per square meter or 1 million nematodes per 100 square feet, depending on the pest severity. Regular monitoring with sticky traps will help gauge pest populations and determine the need for reapplication.
Chemical interventions should be a last resort due to their potential impact on mushroom quality and human health. If necessary, use organic fungicides like potassium bicarbonate or neem oil, applying them at recommended dosages (typically 1-2% solution) and ensuring proper ventilation during application. Always follow label instructions and allow sufficient time between spraying and harvest to avoid residue issues.
Finally, proactive monitoring is essential. Inspect crops daily for signs of disease, such as discoloration or unusual growth patterns, and quarantine affected areas immediately. Keep detailed records of all control measures, environmental conditions, and observations to identify trends and refine strategies over time. By combining rigorous hygiene, environmental control, biological solutions, and targeted treatments, growers can effectively manage pests and diseases in a shipping container, ensuring healthy and productive mushroom cultivation.
Mushrooms as a Potential Pancreatitis Treatment for Dogs: What's Known?
You may want to see also

Harvesting and Yield: Techniques for maximizing mushroom yield and proper harvesting methods in containers
Growing mushrooms in shipping containers offers a controlled environment that can significantly boost yield, but success hinges on precise harvesting techniques. Overharvesting or improper timing can stress mycelium, reducing future flushes. For optimal results, harvest mushrooms when the caps are fully expanded but before the gills begin to drop spores—typically 5-7 days after primordia formation. Use a sharp knife or twisting motion to avoid damaging the substrate, and always sanitize tools with 70% isopropyl alcohol between cuts to prevent contamination.
Maximizing yield requires understanding the container’s microclimate. Maintain humidity at 85-95% and temperatures between 60-75°F (15-24°C) during fruiting. Introduce fresh air via passive ventilation or a small fan to replenish CO2 levels, as mushrooms require it for healthy growth. Light exposure is minimal—a 12-hour photoperiod with low-intensity LED lights suffices. Regularly monitor pH levels in the substrate (ideal range: 5.5-6.5) and adjust with lime or gypsum if deviations occur.
A comparative analysis of harvesting methods reveals that staggered harvesting—removing mature mushrooms daily rather than all at once—prolongs the fruiting cycle. This approach allows younger mushrooms to develop without competition for resources. Additionally, reusing the substrate for 2-3 flushes is feasible with proper care, though yields decrease by 20-30% after the first harvest. For oyster mushrooms, expect 1-2 pounds per square foot per flush; shiitake yields are lower, averaging 0.5-1 pound per square foot.
To enhance yield, supplement the substrate with nitrogen-rich additives like coffee grounds or soybean meal during colonization. Avoid overwatering, as excess moisture fosters mold and bacteria. Instead, mist the container walls to maintain humidity without saturating the growing medium. For advanced growers, consider integrating a CO2 monitor to ensure levels remain below 1,000 ppm, as higher concentrations inhibit fruiting.
Finally, proper post-harvest handling preserves quality and extends shelf life. Store harvested mushrooms in breathable containers (e.g., paper bags) at 35-40°F (2-4°C) with 90-95% humidity. For long-term storage, dehydrate mushrooms at 125°F (52°C) for 6-8 hours, reducing their weight by 80-90% while retaining flavor. By combining these techniques, container-grown mushrooms can achieve yields rivaling traditional farms, making this method both scalable and profitable.
Are White Mushrooms Keto-Friendly? A Low-Carb Diet Guide
You may want to see also
Frequently asked questions
Yes, shipping containers can be repurposed into controlled environments for growing mushrooms. They provide a compact, insulated space that can be equipped with the necessary systems for temperature, humidity, and ventilation control.
Modifications include adding insulation, installing HVAC systems for climate control, setting up shelving or racks for mushroom beds, ensuring proper lighting, and incorporating humidity control systems like misters or humidifiers.
A wide variety of mushrooms can be grown, including oyster, shiitake, lion's mane, and button mushrooms. The choice depends on the specific growing conditions you can maintain within the container.